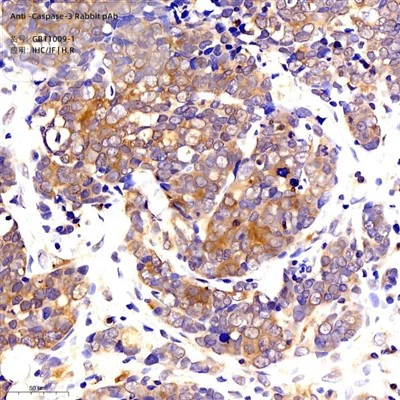
Anti-caspasa -3 conill PAB

Informació de prodoctància
Informació del producte
|
Nom complet de proteïnes |
Glicoproteïna superficial de cèl·lules T Cadena Epsilon |
|
Sinònims |
CD3E, IMD18, T3E, TCRE, CD3E MOLECULE |
|
Immunogen |
Pèptid sintètic conjugat KLH corresponent al CD3 del ratolí |
|
Uniprot identificador |
P22646 |
|
Isotip |
Igg |
|
Puresa |
Purificació d’afinitat |
|
Ubicació subcel·lular |
Membrana cel·lular |
|
MW predit. \/ MW observat. |
21 kDa \/ 21 kDa |
Aplicacions
|
Aplicacions |
Espècie |
Dilució |
Mostra positiva |
|
WB |
Humà, ratolí, rata |
1:500-1:1000 |
Thimus, ganglis limfàtics |
|
Ihc\/si |
Humà, ratolí, rata |
1:250-1:1000 |
Medra, esplenitis, amígdala |
Fons
La proteïna codificada per aquest gen és el polipèptid Cd 3- epsilon, que juntament amb Cd 3- gamma, -Delta i -zeta, i el receptor de cèl·lules T alfa\/beta i heterodímers gamma\/delta, forma el complex receptor de cèl·lules T -CD3. Aquest complex té un paper important en el reconeixement de l'antigen d'acoblament a diverses vies intracel·lulars de transducció de senyal. Els gens que codifiquen els polipèptids Epsilon, Gamma i Delta es troben al mateix clúster al cromosoma 11. El polipèptid Epsilon té un paper essencial en el desenvolupament de les cèl·lules T.
Imatges
|
|
Anàlisi de Western blot de CD3 (GB11014) a la dilució de 1: 500 |
 |
Immunohistoquímica de la parafina Incrustada amígdina humana mitjançant CD3 (GB11014) a la dilució de 1: 1000 (lent 400x) |
 |
Immunohistoquímica de la parafina Embedded Mouse Spleen mitjançant CD3 (GB11014) a dilució de 1: 1000 (lent 400x) |
 |
Immunohistoquímica de la parafina Esplenitis de ratolí incrustat mitjançant CD3 (GB11014) a dilució de 1: 1000 (lent 400x) |
 |
Immunohistoquímica de la parafina Embedded Spleen mitjançant CD3 (GB11014) a dilució de 1: 1000 (lent 400x) |
 |
Immunofluorescència de la tonsil humana incrustada per parafina mitjançant CD3 (GB11014) a dilució de 1: 500 (lent 200x) |
 |
Immunofluorescència de la tonsil humana incrustada per parafina mitjançant CD3 (GB11014) a dilució de 1: 500 (lent 400x) |
 |
Immunofluorescència de la melsa de ratolí incrustat per parafina mitjançant CD3 (GB11014) a dilució de 1: 500 (lent 400x) |
Magatzem
| Magatzem | Emmagatzemeu al grau -20 durant un any. Eviteu els cicles de congelació\/ descongelació repetits. |
| Tampó d'emmagatzematge | PBS amb 0. 02% Azide de sodi, 100ug\/ml BSA i 50% glicerol. |
NOTA:
1. Aquest producte està destinat només a la investigació.
2. Aquest producte es recomana diluir amb el tampó de dilució d’anticossos primari (G2025).
返回列表
Etiquetes populars: Fabricants de conill anti-CD3, Xina Anti-CD3 PAB PAB, proveïdors, fàbrica, fàbrica